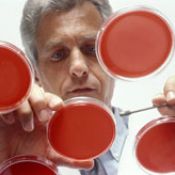

- « Previous
- May 2007
- Next »
- Archives
- About iBi
Features
Columns
Patrick Kirchhofer - Peoria County Farm Bureau
Mike Waight, IMEC
Brent Lonteen, Peoria Area Convention & Visitors Bureau